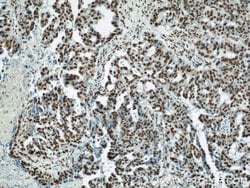
MAD2L1 Rabbit anti-Human, Mouse, Rat, Polyclonal, Proteintech 150 &mu;L;

missing translation for 'onlineSavingsMsg'
Learn More
Learn More
MAD2L1 Rabbit anti-Human, Mouse, Rat, Polyclonal, Proteintech
Rabbit Polyclonal Antibody
Brand: Proteintech 10337-1-AP-150UL
This item is not returnable.
View return policy
Description
MAD2L1 is a component of the mitotic spindle assembly checkpoint that prevents the onset of anaphase until all chromosomes are properly aligned at the metaphase plate. MAD2L1 is related to the MAD2L2 gene located on chromosome 1. A MAD2 pseudogene has been mapped to chromosome 14.Specifications
| MAD2L1 | |
| Polyclonal | |
| Unconjugated | |
| MAD2L1 | |
| HSMAD2, MAD2, MAD2 like protein 1, MAD2L1 | |
| Rabbit | |
| Antigen Affinity Chromatography | |
| RUO | |
| 297176, 4085, 56150 | |
| -20°C | |
| Liquid |
| Immunocytochemistry, Immunofluorescence, Immunohistochemistry (Paraffin), Immunoprecipitation, Western Blot | |
| 0.21 mg/mL | |
| PBS with 50% glycerol and 0.1% sodium azide; pH 7.3 | |
| Q13257, Q9Z1B5 | |
| Mad2l1 | |
| MAD2L1 Fusion Protein Ag0307 | |
| 150 μL | |
| Primary | |
| Human, Mouse, Rat | |
| Antibody | |
| IgG |
Product Content Correction
Your input is important to us. Please complete this form to provide feedback related to the content on this product.
Product Title
Spot an opportunity for improvement?Share a Content Correction